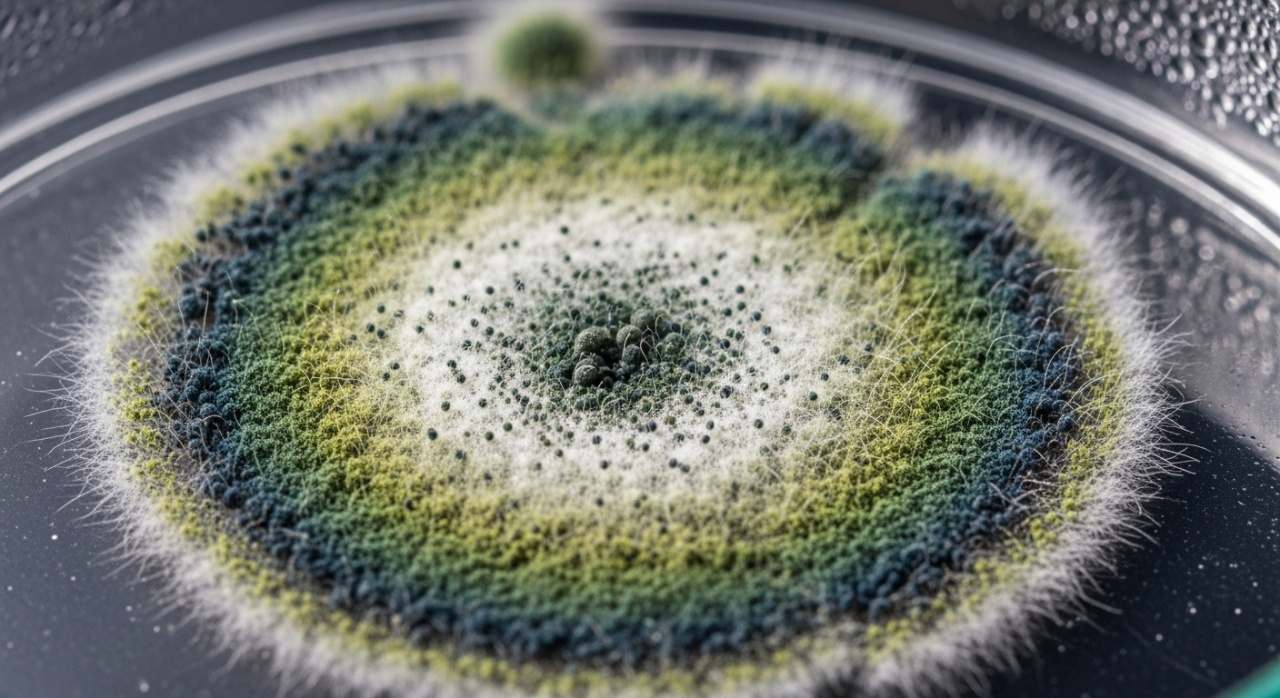

アスペルギルス・ニガーの特徴と健康被害! プロが解説する正しいカビ除去とカビ予防方法
2026/03/27
こんにちは、MIST工法®カビバスターズ本部です。日頃から、私たちは全国各地のお客様のお住まいや職場で発生するカビの問題と真摯に向き合い、確かな技術と豊富な知識で快適な住環境をサポートしています。さて、皆さんは「アスペルギルス・ニガー(Aspergillus niger)」というカビをご存じでしょうか?見た目が黒いため「黒カビ」として分類されることもありますが、日常でよく目にする一般的な黒カビ(Cladosporium属)とは異なる種類の真菌です。
アスペルギルス・ニガーは湿度の高い場所に好んで繁殖し、特に浴室やキッチン周辺、さらにはエアコンのフィルター内などにもよく見られます。見た目の不快さはもちろんですが、実はこのカビが引き起こす健康への影響は決して軽視できません。特に免疫力が低下している方の場合、肺アスペルギルス症という深刻な肺感染症を引き起こす可能性があります。また、耳に胞子が入り込むことによって外耳道炎(真菌性外耳道炎)という耳の病気を発症する恐れもあります。
本ブログでは、そんなアスペルギルス・ニガーの正しい知識を皆さまにお届けするとともに、プロだからこそできる専門的な対処法や予防策を詳しくご紹介いたします。日本全国に展開するMIST工法®加盟のカビバスターズ・カビ取リフォーム・カビバスター隊が、安心・安全な住まいづくりのお手伝いをさせていただきますので、どうぞ最後までお付き合いください。
目次
意外と身近に潜むカビ「アスペルギルス・ニガー」
アスペルギルス・ニガー(Aspergillus niger)とは?
アスペルギルス・ニガー(Aspergillus niger)は、俗に「黒カビ」の一種として知られています。しかし一般的に家庭内で多く見られる黒カビ、つまりCladosporium属のカビとは生態的にも病理学的にも異なる特徴を持った真菌(カビ)です。名前の由来はラテン語で、Aspergillusは「散水器」を意味し、顕微鏡で見ると胞子が散水器のような形状をしているため名付けられました。またnigerは「黒い」を意味し、その名の通り黒色の胞子を形成する特徴的なカビです。
アスペルギルス・ニガーは自然界では広く分布しており、特に湿度の高い場所や温暖で換気が悪い室内環境に繁殖しやすいことから、日本の住宅環境では非常に身近な存在となっています。住宅では特に浴室やトイレなどの水回り、エアコン内部のフィルターや換気口、さらにキッチンなど湿気や結露が多く発生する場所で頻繁に見られます。その繁殖力は強く、一度繁殖が始まると短期間で広がり、目に見える黒い斑点状の汚れとして現れるのが特徴です。
また、アスペルギルス・ニガーは健康面でも無視できない影響を及ぼします。一般的には免疫が正常な人には重大な病気を引き起こすことは稀ですが、高齢者や小さなお子様、病気や治療などで免疫力が低下している方にとっては、肺感染症(肺アスペルギルス症)や外耳道炎(真菌性外耳道炎)などを引き起こすリスクがあります。特に肺アスペルギルス症は、肺内で胞子が発芽して菌糸を形成し、慢性的な呼吸器症状や、まれに重篤な状態へと進行するケースもあります。また、耳の内部に胞子が入り込んだ場合には激しいかゆみや痛みを伴う外耳道炎が発症し、慢性的に繰り返すケースもあります。
アスペルギルス・ニガーは産業的にも食品産業でクエン酸などの発酵生産に利用されることがありますが、住宅環境では深刻な問題を引き起こすことが多く、早急かつ適切な対処が求められます。近年、住環境の密閉性が高まったことで室内の湿度管理が難しくなり、カビが発生しやすい環境となっています。そのためアスペルギルス・ニガーに関する正確な知識を身につけ、繁殖予防や適切な除去方法を理解することが、快適で健康な生活を維持するために極めて重要となっています。
本ブログでは、アスペルギルス・ニガーについて詳しく解説し、MIST工法®カビバスターズの専門的な知識と技術で皆さまの健康で快適な暮らしをサポートいたします。
アスペルギルスニガーの特徴と黒カビとの違い
同じ「黒カビ」でも全く異なるアスペルギルス・ニガーとCladosporium属を専門家が徹底解説!
【外見・生態の特徴】
アスペルギルス・ニガー(Aspergillus niger)は、その名が示すとおり黒色の胞子を形成することが大きな特徴です。顕微鏡で見ると、胞子が放射状に広がり、「散水器」のような特徴的な形状(胞子頭)を形成しています。この胞子は非常に小さく軽量であり、空気中を容易に浮遊して広範囲に拡散する性質があります。そのため、換気が不十分で湿気が多い空間では特に増殖しやすく、短期間で目に見える黒色の斑点状に広がります。
生態的には、アスペルギルス・ニガーは糖類や澱粉質を含む有機物を栄養源としており、特に水分を含んだ壁紙や木材、ホコリが溜まったエアコン内部のフィルターなどを好んで繁殖します。繁殖速度が速く、適温(20~30℃)と高湿度(60%以上)が揃うと爆発的に増殖します。また、このカビは耐乾燥性も比較的高く、一度繁殖した場所では乾燥状態になっても再び湿度が上がると活動を再開しやすいため、注意が必要です。
さらにアスペルギルス・ニガーは、特定の条件下ではマイコトキシン(真菌毒素)を産生する可能性も報告されており、健康へのリスクを高める要素を含んでいます。日常生活において身近な存在でありながらも、放置すると健康や住環境に悪影響を与える可能性が高いため、早急な対策が求められます。
【一般的な黒カビ(Cladosporium属)との違いについて】
一般的に家庭内で目にする黒カビとされるのがCladosporium属の真菌ですが、これはアスペルギルス・ニガーとは異なる特徴を多数持っています。まず外見的な特徴として、Cladosporium属は胞子が比較的大きく、顕微鏡で観察すると鎖状に連なった胞子が特徴的です。アスペルギルス・ニガーが放射状に広がる胞子頭を形成するのに対し、Cladosporium属はシンプルな枝状の構造を持ち、肉眼では広がったシミ状に見えることが一般的です。
生態面でも大きな違いがあります。Cladosporium属は比較的乾燥にも強く、湿度が高くない環境でもゆっくりと成長を続けることができます。逆にアスペルギルス・ニガーは高湿度環境を非常に好み、急速に増殖する点が大きな差異です。また、繁殖する場所についても違いがあり、Cladosporium属は窓際や壁の表面、布製品などの比較的乾燥した表面にもよく現れますが、アスペルギルス・ニガーは特に水回りやエアコン内部など湿度が高く、水分が豊富な場所に好んで発生します。
健康への影響でも差があり、Cladosporium属は主にアレルギー性鼻炎や喘息の原因となりますが、重篤な感染症はほとんど引き起こしません。一方、アスペルギルス・ニガーは免疫低下者に肺感染症や外耳道炎などのより深刻な症状を起こすことがあり、健康リスクがより高いことも特徴です。そのため、アスペルギルス・ニガーを確認した場合は特に慎重な対応が求められます。
アスペルギルス・ニガーが繁殖しやすい環境と場所
放置すると危険!アスペルギルス・ニガーが好む住環境とは?
【浴室・キッチンなど水回り】
浴室やキッチンはアスペルギルス・ニガーが特に繁殖しやすい場所の代表格です。これらの場所は日常的に水を使い、頻繁に濡れたり乾いたりを繰り返すことで湿度が常に高い状態に保たれています。特に浴室は入浴による蒸気や水滴が壁や天井、浴槽の周囲に付着しやすく、換気が不十分な場合には湿気が長期間滞留します。この湿った環境はアスペルギルス・ニガーが好む条件であり、特にタイルの目地やシリコン部分、排水口周辺に黒色の斑点状に発生することが多く見られます。また、キッチンでもシンクや蛇口周辺、排水管内部、さらには冷蔵庫や食器棚の裏側など、目につきにくい場所での繁殖も多発しています。食品の残渣や有機物が多く存在するため、栄養源が豊富であり、カビの繁殖が進みやすいのです。水回りにおいてアスペルギルス・ニガーを防ぐためには、使用後に水分を拭き取る習慣や換気をしっかりと行い、カビの栄養源となる有機物をこまめに取り除くなど、日頃の管理と衛生的な環境維持が非常に重要になります。
【エアコンや空調設備のフィルター】
アスペルギルス・ニガーが繁殖しやすい場所として意外に見落とされがちなのがエアコンや空調設備のフィルターです。エアコンは室内の空気を循環させるため、多くの空気中の埃や湿気を吸い込みます。フィルターにはこうした埃や微小な有機物が溜まりやすく、適切な清掃を怠るとカビが増殖するための絶好の条件が整ってしまいます。特に梅雨時期や夏季の冷房使用時には、結露によりフィルター内が常に湿った状態になり、アスペルギルス・ニガーが急速に繁殖します。これが放置されるとエアコンの風とともに大量の胞子が室内へ放出され、空気中に拡散するため、呼吸器系の健康被害を引き起こすリスクが高まります。喘息やアレルギー症状を誘発したり、免疫力の低い方には肺感染症を引き起こす可能性があります。そのため、エアコンのフィルターは定期的な清掃と消毒を実施し、繁殖を未然に防ぐことが重要です。専門業者による定期的なクリーニングを行うことで、安心・安全な空調環境を維持できます。
【壁や天井など湿度が高い場所】
壁や天井といった場所もアスペルギルス・ニガーが頻繁に発生する場所の一つです。特に建物の断熱性や気密性が高くなった現在では、室内外の温度差が大きくなりやすく、結露が発生しやすい環境が整っています。冬季など外気温と室内温度との差が大きい場合、壁や天井の内側や表面に結露が起こります。この結露はカビが好む湿潤環境を作り出し、アスペルギルス・ニガーが広がる原因となります。壁紙や塗装面に一度カビが発生すると、除去が難しく、放置すると壁材内部まで侵食されることもあり、構造材の劣化にもつながります。さらに見えない壁内部で繁殖した場合には気付かないうちに広がり、健康に影響を及ぼす胞子を室内に拡散し続けることもあります。壁や天井での繁殖を防ぐためには、定期的な換気による湿度管理や適切な断熱対策が必須です。また、湿気が多い季節には除湿機を活用するなど、湿度を50~60%以下に維持する環境づくりが効果的です。さらに、建物の異変を感じたら速やかに専門業者に相談し、早期に対処することが重要となります。
アスペルギルス・ニガーが引き起こす主な病気と健康影響
見逃さないで!アスペルギルス・ニガーがもたらす健康リスクと症状を詳しく解説
【肺アスペルギルス症とは?】
肺アスペルギルス症とは、アスペルギルス属のカビの胞子を吸い込むことで肺内に感染を起こす病気です。アスペルギルス・ニガーもこの疾患の原因菌の一つとして知られており、特に免疫力が低下した方、高齢者、基礎疾患を持つ方などにとっては注意が必要な病気です。胞子が肺内で発芽し菌糸を形成すると、肺組織が侵されて咳や痰、息切れ、胸痛、倦怠感などの症状が現れます。重症になると呼吸困難や肺機能の低下を引き起こし、治療が遅れると生命を脅かす可能性もあります。特に注意が必要なのは、慢性肺疾患や肺結核などの既往歴がある方や、免疫抑制剤治療、ステロイド長期投与、抗がん剤治療を受けている方です。これらの方々は感染リスクが高く、アスペルギルス・ニガーをはじめとする真菌感染症の早期発見と適切な治療が必須です。また、症状が風邪や気管支炎と似ているため、感染が長期間見過ごされるケースもあります。疑わしい症状が長引く場合は、専門医への受診と精密な診断が求められます。
【外耳道炎(真菌性外耳道炎)の症状と特徴】
外耳道炎(真菌性外耳道炎)は、耳の外耳道にアスペルギルス・ニガーなどのカビの胞子が侵入・繁殖することによって引き起こされる疾患です。主な症状は、耳のかゆみや痛み、違和感、耳漏(耳からの分泌物)、耳鳴り、難聴感などが挙げられます。特に初期症状としてかゆみが多く、耳掃除のし過ぎや湿気がこもりやすい環境が感染リスクを高めます。また、夏季や梅雨時など湿気が多い季節に発症が多いのも特徴です。症状が進行すると痛みや炎症が強くなり、耳の内部が赤く腫れる、黒色や灰色のカビ状の分泌物が見られることもあります。免疫が低下した方だけでなく、水泳や入浴後に耳を十分に乾燥させないまま放置した場合にも発症しやすくなります。真菌性外耳道炎は治療が長期化する傾向があり、放置すると慢性化して何度も再発を繰り返すことがあります。そのため、早期に耳鼻咽喉科で診察を受け、抗真菌薬を用いた適切な治療を行うことが非常に重要です。
【外耳道炎(真菌性外耳道炎)の症状と特徴】
アスペルギルス・ニガーは肺や耳の感染症以外にもさまざまな健康リスクをもたらします。特に注意が必要なのはアレルギー症状の誘発です。カビ胞子を吸入することでアレルギー性鼻炎や喘息の症状が悪化することがあります。これらの症状は咳、くしゃみ、鼻水、目のかゆみ、皮膚のかゆみなどとして現れ、日常生活に大きな支障をきたします。また、長期間カビにさらされ続けると、特に小さなお子様や高齢者では慢性的な咳や気管支炎、皮膚疾患を引き起こすこともあります。さらに、免疫不全状態の方においては、皮膚感染症や深在性真菌症といったより深刻な症状へと進行する場合があります。アスペルギルス・ニガーが繁殖した室内環境では、呼吸器系を中心とした慢性疾患が多発しやすくなるため、日頃から室内のカビ対策と湿度管理を徹底することが、健康リスクを軽減するために非常に重要となります。健康被害を防ぐためにも、カビの兆候を見つけた場合は専門家による診断と適切な除去対策が必要です。
アスペルギルス・ニガーの正しい除去方法
専門技術「MIST工法®」で徹底除去―アスペルギルス・ニガーを根本から解決!
【MIST工法®によるカビ除去のメカニズム】
MIST工法®とは、カビの除去と予防を目的とした専門的な施工法であり、アスペルギルス・ニガーを含め様々なカビの完全除去に高い効果を発揮します。MIST工法®の最大の特徴は、特殊な専用溶剤を極めて微細なミスト状にして噴霧することにあります。微粒子状にすることで溶剤が室内のすみずみまで行き渡り、壁や天井の表面だけでなく、通常の施工では届きにくい建材の奥深くに入り込んだカビ菌や胞子にも浸透します。その結果、表面的な除去にとどまらず、カビの菌糸や胞子を根こそぎ不活化・分解することが可能となります。また、MIST工法®で使用する溶剤は環境に配慮され、安全性にも優れており、施工後の人体への影響も極めて低いことが特徴です。施工後は特殊なコーティング剤を併用することにより、カビが再発しにくい環境を作り出し、持続的な予防効果を実現します。このメカニズムによって、アスペルギルス・ニガーなどの強力なカビに対しても、効果的で長期的な除去・防止が可能となり、安心・安全な住環境が維持できます。
【実際の施工事例とその効果について】
アスペルギルス・ニガーが発生した実際の施工事例として、ある戸建住宅の浴室およびエアコン内のカビ除去のケースをご紹介します。この事例では、浴室の壁や天井に黒い斑点が広範囲に繁殖しており、エアコン内部にもカビが大量に繁殖している状態でした。MIST工法®による施工では、まず専用溶剤をミスト状にして浴室全体やエアコン内部にくまなく噴霧し、隠れたカビの菌糸や胞子を完全に不活化しました。その後、専門的な洗浄処理を行い、仕上げに抗菌コーティングを施すことで施工が完了しました。施工後には目に見える黒いカビは完全に消え去り、気になるカビ特有の臭いも消滅しました。また、施工後の定期的な調査によって、半年以上経過してもカビの再発は一切認められず、衛生的な室内環境を長期間保っています。このような事例は多数あり、MIST工法®がアスペルギルス・ニガーをはじめ、難易度の高いカビ除去にも非常に高い効果を発揮することが証明されています。
【一般的な除去法との違いとメリット】
一般的なカビの除去法としては、家庭用の漂白剤やアルコールなどの消毒剤を使った簡易的な拭き取り作業があります。しかし、このような除去法は表面的な菌を一時的に取り除くだけであり、建材内部や隙間などに入り込んだ菌糸や胞子を完全に除去することができません。その結果、短期間で再発を繰り返すケースが非常に多く見られます。一方、MIST工法®は微粒子ミストによって、深部に浸透し、見えない箇所の菌糸や胞子を根本から除去することが可能です。また、安全性が高く、環境に配慮された溶剤を使用しているため、健康への影響が少なく、施工後もすぐに日常生活に戻ることができます。さらに、再発防止のコーティングを施すことにより、長期的なカビ予防効果を得られる点が大きなメリットです。施工後のメンテナンスの頻度やコストも大幅に軽減され、住環境の衛生状態を長期間にわたって維持できることから、専門業者によるMIST工法®の採用が非常に効果的であり、多くのお客様に選ばれています。
よくある質問(Q&A)
知って安心!アスペルギルス・ニガーに関する疑問にプロがお答えします
Q1:アスペルギルス・ニガーと一般的な黒カビは、どうやって見分けることができますか?
アスペルギルス・ニガーと一般的な黒カビ(Cladosporium属)は外見的には似ていますが、繁殖する場所や速度が異なります。アスペルギルス・ニガーは特に湿度の高い浴室やエアコン内部などに多く見られ、比較的短期間で濃い黒色の斑点が広がります。一般的な黒カビは、やや乾燥した環境でも発生し、ゆっくりとシミ状に広がる傾向があります。ただし、正確な判別には専門家による顕微鏡を用いた検査が必要です。
Q2:アスペルギルス・ニガーを放置すると具体的にどんな病気になる可能性がありますか?
アスペルギルス・ニガーを長期間放置すると、特に免疫力が低下した方や高齢者、小さなお子様は肺アスペルギルス症や真菌性外耳道炎などを発症するリスクが高まります。また、慢性的な喘息やアレルギー性鼻炎の悪化を引き起こす可能性もあります。健康な方でもアレルギー症状が悪化することがあり、注意が必要です。
Q3:市販の漂白剤やカビ取り剤で十分除去できますか?
市販の漂白剤やカビ取り剤は一時的な表面的除去には有効ですが、アスペルギルス・ニガーが深部まで繁殖した場合、これらの方法では完全に除去することは困難です。特に壁や建材内部、エアコン内部などに侵入した場合は専門的な施工(MIST工法®など)が必要です。
Q4:アスペルギルス・ニガーの除去後、再発を防ぐにはどうすれば良いでしょうか?
再発防止には、除去後の継続的な湿度管理と換気が重要です。MIST工法®施工後には、再発防止効果のある専用コーティングを施し、日常の換気と湿度調整を組み合わせることで、長期間カビの発生を防ぐことが可能です。
Q5:MIST工法®施工は人体やペットに安全ですか?
MIST工法®で使用される溶剤は環境配慮型で、安全性の高い成分を用いています。人体やペットへの影響は極めて少なく、施工後すぐに安心して通常の生活に戻ることができます。また、施工時には専門スタッフが安全管理を徹底して行っていますので、ご安心ください。
このように、アスペルギルス・ニガーに関する正しい知識を持つことで、適切な対処が可能となります。MIST工法®カビバスターズ本部では、全国各地で無料相談やお見積りを承っていますので、お気軽にお問い合わせください。
まとめ
健康と財産を守るために―カビ対策の重要性とプロに依頼するメリット
【健康で快適な生活を守るために必要なこと】
アスペルギルス・ニガーのようなカビは、単に見た目の問題にとどまらず、私たちの健康や生活環境に重大な影響を与えます。そのため、日常生活の中でカビの予防・管理を徹底することが非常に重要です。まずは毎日のこまめな掃除や定期的な換気を行い、湿気がこもらない環境を作り出すことが基本となります。特に湿度管理は重要で、湿度を50~60%以下に維持することで、多くのカビの発生を抑えることができます。除湿機やエアコンを活用し、適切な換気を習慣化しましょう。また、浴室やキッチンなど湿気が発生しやすい場所では、水滴を拭き取る習慣をつけ、カビの栄養源となるホコリや汚れを定期的に除去することが大切です。さらに、見落としがちなエアコンのフィルターや壁紙の裏側など、隠れた場所への注意も必要です。定期的に室内環境の点検を行い、カビの兆候が見つかった場合は迅速に対応することで、健康被害を未然に防ぎ、快適な生活を維持することが可能になります。カビ予防は日々の積み重ねが何よりも重要です。早期発見・早期対処を意識して、家族の健康を守り、住まいを清潔で快適な空間として保つことを心がけましょう。
【専門業者に依頼するメリットとは?】
カビ対策を専門業者に依頼する最大のメリットは、徹底的かつ長期的な効果を期待できることです。アスペルギルス・ニガーなどのカビは、表面的に取り除くだけでは根本的な解決にならず、短期間で再発するケースが多くあります。専門業者によるMIST工法®施工では、特殊な溶剤を微細なミスト状にして噴霧することで、建材の深部に入り込んだ菌糸や胞子まで完全に除去できます。そのため、一度の施工で徹底的にカビを取り除くことが可能です。また、施工後には再発防止効果を高めるための抗菌コーティング処理が施され、長期的にカビが発生しにくい環境を作り出します。さらに、専門業者はカビの種類や発生原因を正確に診断し、効果的な対策を提案します。そのため、自己流で行う除去作業による失敗や二次被害のリスクがありません。人体に安全で環境にも配慮された施工方法を採用しているため、安心して生活を続けることができます。専門家ならではの高い技術力と豊富な経験に基づいた施工によって、健康へのリスクを低減し、建物の資産価値の低下を防ぎ、長期的な経済的メリットも得られるのです。カビ問題に直面した際は、早めに専門業者に相談・依頼することをおすすめします。
------------------------------------------------------------------------------------------------------------------------
カビ取り・カビ対策専門業者MIST工法カビバスターズ本部
0120-052-127(平日9時から17時)
カビの救急箱
【検査機関】
一般社団法人微生物対策協会
------------------------------------------------------------------------------------------------------------------------